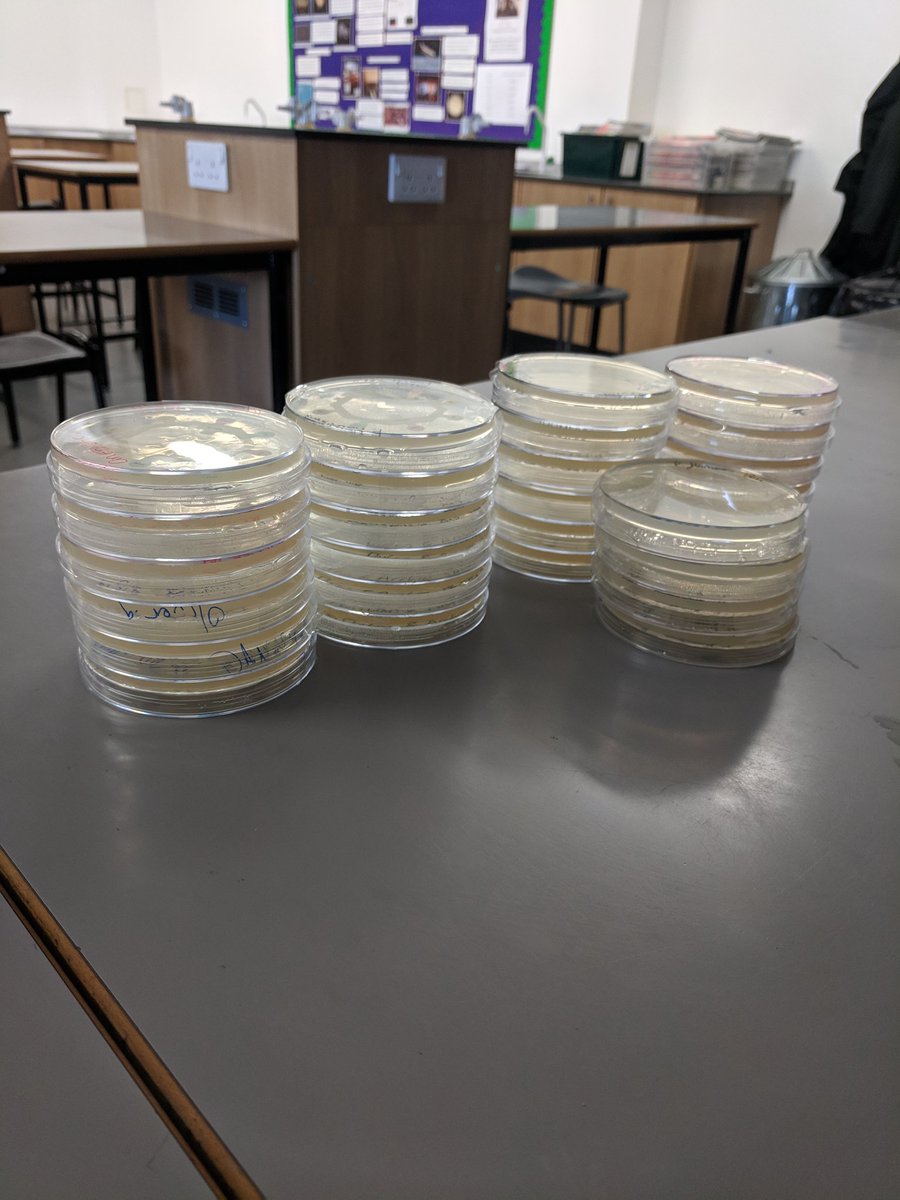
Great technique shown by many of Y10 as they made their antibiotic ZOI and streak plates today, looking forward to the results on Friday. Definitely some potential #futuremicrobiologists in <a href="/CVScienceDept/">Laura Watford</a> at <a href="/CastleviewUl/">CastleviewUL</a>!

Ben McDonagh
@2ndry_microbiol

Really interesting first day at the Teach First #TDC2018 including a great talk from Tom Sherrington on the value of meaningful and productive feedback in marking.

And that's the first day's teaching done with tomorrows lessons planned. Meeting the students makes it real. Teach First




Some really interesting ideas shared last night for making waves more understandable and relevant at a great session run by the Institute of Physics. Also a great chance to speak with local colleagues and learn from the experiences of others! #STEMed




Great technique shown by many of Y10 as they made their antibiotic ZOI and streak plates today, looking forward to the results on Friday. Definitely some potential #futuremicrobiologists in Laura Watford at CastleviewUL!